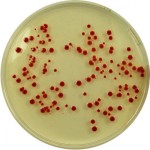

Una enfermedad que causan las bacterias que se encuentran en los mariscos, anteriormente limitados hasta el Pacífico Noroeste de los Estados Unidos, está presentando las mismas condiciones en la Costa Este mariscos y en Europa, un nuevo informe advierte.
La bacteria, Vibrio parahaemolyticus, es la causa más común ligado a enfermedad del estómago. Hasta hace poco, los mariscos del Pacífico albergaba las cepas más virulentas de Vibrio, pero no se reportaron brotes de la costa atlántica de los Estados Unidos y en España este año y en 2012.
La bacteria, Vibrio parahaemolyticus, es la causa más común ligado a enfermedad del estómago. Hasta hace poco, los mariscos del Pacífico albergaba las cepas más virulentas de Vibrio, pero no se reportaron brotes de la costa atlántica de los Estados Unidos y en España este año y en 2012.
«Esto es particularmente notable debido a las enormes distancias, a unos 3.000 kilómetros del Pacífico al Atlántico, y 3.000 kilómetros de la costa este de los EE.UU. a Europa», dijo el investigador Craig Baker- Austin , del Centro para el Medio Ambiente , Pesca y Acuicultura Ciencias en Weymouth, Inglaterra.
Las bacterias se encuentran normalmente en los mariscos crudos como ostras y almejas.
Trabajando con colegas de los EE.UU. Centros para el Control y Prevención de Enfermedades, la FDA y el Centro Europeo de Prevención y Control de Enfermedades, dijo Baker- Austin se hizo evidente que estas cepas virulentas causan la enfermedad en nuevas áreas.
En una carta de investigación publicada en la edición del 17 de octubre de la New England Journal of Medicine, el equipo internacional de colaboradores informes sobre la propagación de la Pacific Northwest Vibrio en 2012.
Ese año, el CDC identificó 28 casos en nueve estados a los mariscos vinculadas a Oyster Bay Harbor en Nueva York. Otras 51 personas se enfermaron en un barco de cruceros en España a causa de mariscos cocidos que se enfríaran con hielo hecho con agua de mar contaminado.
Vibrio suele causar nada más que problemas digestivos, incluyendo vómitos, dolor abdominal y diarrea. Sin embargo, las personas con sistemas inmunológicos debilitados pueden sufrir síntomas graves y potencialmente mortales.
Un médico dijo que los consumidores no deben comer los mariscos de manera indiscriminada. «La gente debe ser consciente de donde su comida está viniendo, » dijo el Dr. Jacqueline Moline , presidente de salud de la población a la orilla LIJ Health System del Norte en Manhasset , NY » Hay riesgos significativos para comer alimentos crudos o poco cocinados.»
Las implicaciones del movimiento de larga distancia de Vibrio son desconocidas, pero preocupante, dijo Baker- Austin.
«A mediados de la década de 1990, una variante de Vibrio surgió en Asia y rápidamente se trasladó todo el mundo, causando un gran número de infecciones «, dijo Baker- Austin. «Aunque esto todavía no ha sucedido con estas cepas noroeste del Pacífico, la posibilidad de que esto ocurra se debe reconocer y evaluar adecuadamente».
Este año en los Estados Unidos, el cierre de marisqueo en seis estados y cuatro en el noreste – se atribuyó a Vibrio.
Los investigadores no están seguros de por qué o cómo Vibrio se ha extendido, pero sospechan que la interferencia humana. Es posible que el agua de lastre de los buques o transporte de larga distancia hagan llegar las bacterias a nuevas regiones, sugirieron .
Moline dijo que el calentamiento global puede desempeñar un papel en el crecimiento de Vibrio.
«Más alto que la temperatura normal del agua de mar están asociados con el aumento de la prevalencia de esta cepa bacteriana y enfermedades relacionadas con ella», dijo Moline.
Dado que los océanos continúan calentándose, probablemente aparecerán más enfermedades transmitidas por los alimentos, dijo.» La gente tiene que ser consciente de cómo los cambios ambientales pueden estar afectando a todos nosotros, sobre todo en términos de seguridad alimentaria», añadió Moline.
Estas bacterias pueden ser destruidas por cocinar completamente los alimentos , dijo.
Esto es crítico para personas inmunodeprimidas, particularmente aquellos con enfermedad hepática crónica, debido a Vibrio puede causar una enfermedad grave del torrente sanguíneo que es fatal en 50 por ciento de las veces.
Vibrio también puede causar infecciones graves de la piel cuando las heridas abiertas están expuestas al agua de mar caliente.
Baker Austin dijo que la cooperación entre los organismos internacionales – la columna vertebral de esta corriente de investigación » que se requiere para comprender y hacer frente a este tipo de amenazas de enfermedades emergentes. »
Lo que realmente se necesita , agregó, son «mejores sistemas a nivel internacional para identificar, monitorear y reportar estas bacterias y las infecciones asociadas a su debido tiempo . «
vibrio parahaemolyticus






